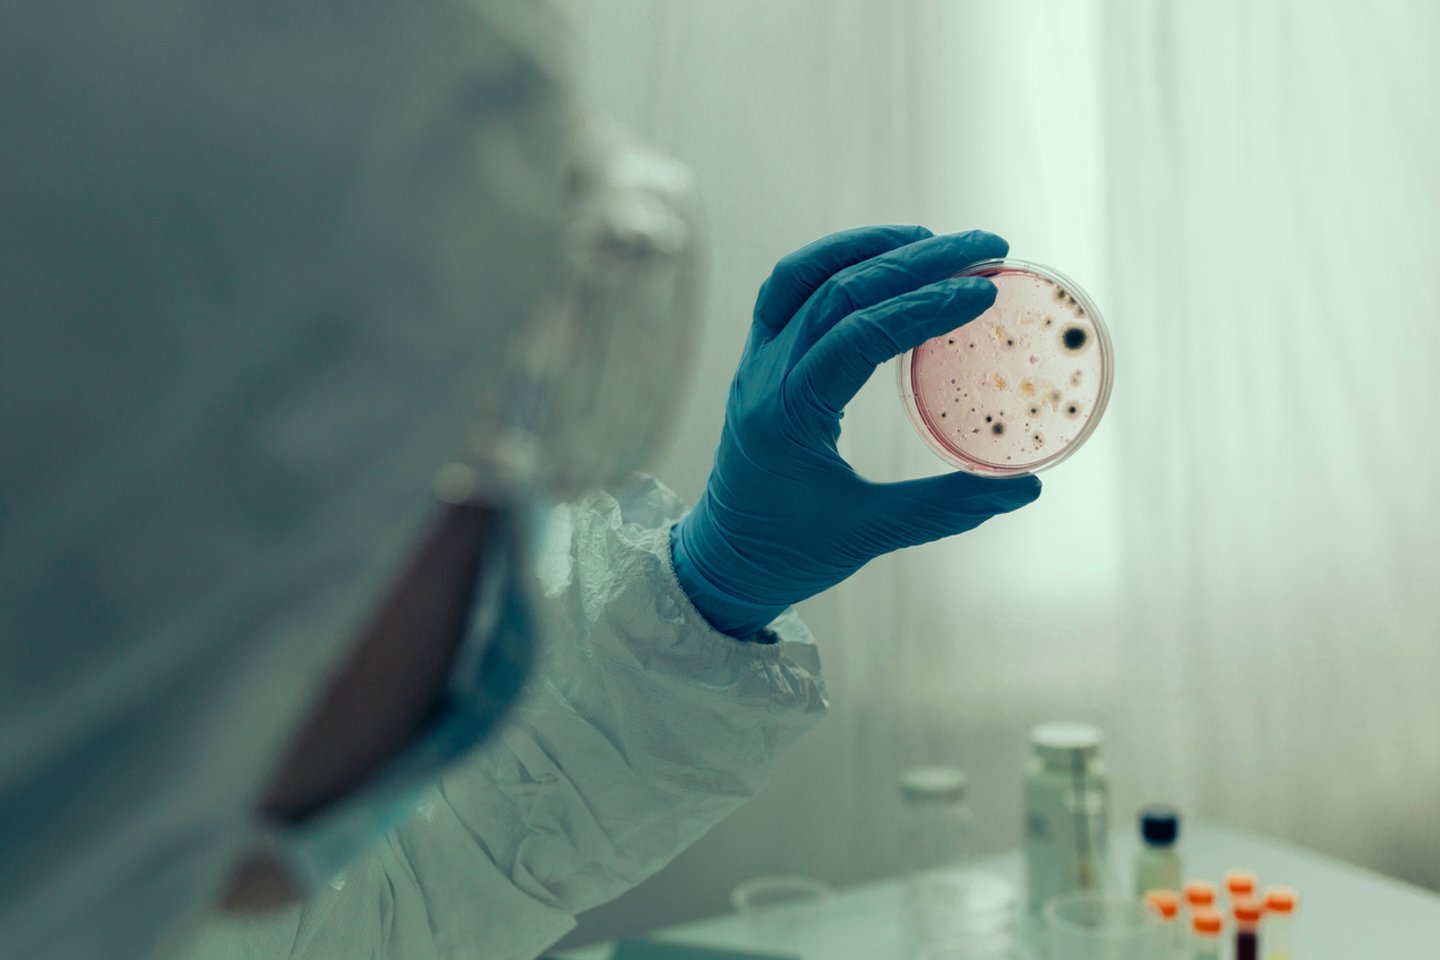

Praėjusią savaitę sveikatos apsaugos pareigūnai Arizonoje (JAV) patvirtino, kad vienas žmogus mirė nuo pneumoninio maro – to paties maro, kuris XIV a. nusinešė beveik pusę Europos gyventojų ir tapo žinomas kaip Juodoji mirtis.
Tuo tarpu JAV fiksuojamas didžiausias tymų protrūkis per pastaruosius dvidešimt metų – Ligų kontrolės ir prevencijos centras (CDC) jau patvirtino daugiau nei 1300 atvejų.
Kai, regis, vis daugiau pamirštų infekcinių ligų ima plisti, kyla klausimas: ar tokie ligų sugrįžimai – normalus reiškinys?
Ieškodami atsakymo, „BBC Science Focus“ žurnalistai kalbėjosi su Paulu Hunteriu – medicinos profesoriumi iš Rytų Anglijos universiteto Noridžo medicinos mokyklos, kuris paaiškino, kodėl ligos sugrįžta, kur slepiasi paskutiniai jų židiniai ir kas galėtų sukelti naują Juodosios mirties bangą.
– Kaip įprasta, kad infekcinės ligos, kurios, rodos, buvo išnykusios, sugrįžta?
– Svarbu ne tiek tai, ar liga dingo, bet ar ji iš tikrųjų buvo išnaikinta. Daugelis anksčiau paplitusių infekcijų niekur nedingo – jos vis dar cirkuliuoja visuomenėje ir gali staiga smogti iš naujo. Pasauliniu mastu per metus paprastai fiksuojama viena ar dvi reikšmingos ligų atsiradimo ar sugrįžimo bangos.
Daugelis klasikinių infekcinių ligų, kurios, regis, vėl atsiranda, iš tiesų tikriausiai niekur nebuvo dingusios – jos tiesiog tyliai egzistavo. Tačiau jų pakartotinis atsiradimas dažniausiai pasireiškia regioniniu mastu. Pavyzdžiui, cholera gali išplisti teritorijoje, kurioje ji nebuvo fiksuota dešimtmečius.
– Ar įmanoma visiškai išnaikinti ligą?
– Tai įvyko tik su raupais. Buvo vilčių, kad pavyks tą patį padaryti su poliomielitu, bet dabar tai atrodo vis mažiau tikėtina. Dauguma infekcijų tiesiog neišnaikinamos. Kai liga išplinta visame pasaulyje ir tampa endemine, ją galima tik valdyti, bet ne visam laikui sunaikinti.
Su raupais padėjo labai veiksminga vakcina, aiškūs simptomai ir stiprus politinis pasiryžimas. Tai leido greitai nustatyti, kur liga plinta, ir ją sustabdyti.
Šiais laikais kyla daugiau problemų – daugelis infekcijų plinta dar prieš pasireiškiant simptomams. Kaip parodė COVID-19 pandemija, nepaprastai sunku suvaldyti infekciją, jei ją platina žmonės, kurie jaučiasi visiškai sveiki.
Be to, sunku suvaldyti ligas konfliktų zonose. Pavyzdžiui, nors turime vakciną nuo Ebolos, Kongo Demokratinėje Respublikoje vykstantis konfliktas sutrukdė efektyviai suvaldyti protrūkį – taip, kaip tai būtų buvę įmanoma taikos metu.
– Kaip ligos sugrįžta?
– Pirmiausia – virusas gali mutuoti. Taip nutinka su gripu: virusas laikui bėgant keičiasi. Kartais įvyksta reikšmingas evoliucinis šuolis, dėl kurio virusas ima sparčiau plisti – tokios mutacijos vadinamos „išsiveržusiomis mutacijomis“ (angl. escaped mutations). Su tokiomis mutacijomis susidūrėme ir COVID-19 pandemijos metu.
Kitas būdas – infekcijos iš gyvūnų pasaulio. Kai kurios ligos – pavyzdžiui, maras – nuolat egzistuoja gamtoje: jis plinta per graužikus. Kai aplinkos pokyčiai priartina žmones prie užkrėstų gyvūnų, kyla pavojus užsikrėsti.
Pavyzdžiui, žmonės JAV kartais užsikrečia maru kontaktuodami su prerijų šuniukais (graužikais) ar medžiodami. Prieš kelis dešimtmečius Madagaskare kilo didelis maro protrūkis, kurį daugiausia lėmė aplinkos nykimas. Dėl šios priežasties šalia žmonių gyvenusios žiurkės pradėjo kontaktuoti su kitais gyvūnais, užsikrėtusiais maru.
Klimato kaita taip pat keičia daugelio ligų geografiją – jos plinta į naujas teritorijas. Pavyzdžiui, Viduržemio jūros pakrantėje Europoje jau fiksuojami nedideli dengės karštligės protrūkiai, nors ši liga paprastai būdinga tik tropiniams regionams.
Didelę reikšmę turi ir skiepijimo lygio sumažėjimas. Tai ir yra pagrindinė tymų plitimo priežastis Jungtinėje Karalystėje.
Kai aš buvau vaikas, persirgti tymais buvo įprasta. Tačiau jaunesni žmonės galbūt niekada nematė nė vieno tymų atvejo, todėl nesupranta, kodėl verta skiepytis. Bet vos tik vakcinacijos lygis sumažėja, tymai gali sparčiai išplisti.
– Kas turėtų nutikti, kad, pavyzdžiui, buboninis maras vėl taptų masine grėsme?
– Marą sukeliančios bakterijos per laiką iš esmės nepakito. Maras vis dar gali būti toks pat pavojingas kaip ir anksčiau, tačiau kadangi tai bakterinė infekcija, turime antibiotikų, kurių viduramžiais žmonės neturėjo – todėl dabar galime ją gydyti.
Liga vis dar gali būti labai sunki ir net mirtina, tačiau, jei taikomas tinkamas gydymas, žmonės dėl maro neturėtų mirti, net jei juo užsikrečia.
Kad situacija taptų nevaldoma, reikėtų visuomenės „žlugimo“ – būtent tai tam tikru mastu vyko Madagaskare. Konfliktai, aplinkos niokojimas ir ekonominė krizė lemia, kad žmonės gyvena arčiau gyvūnų. Dėl to konfliktų zonos dažnai tampa vietomis, kuriose lengviau plinta ligos.
– Kuri infekcinė liga būtų pavojingiausia, jei sugrįžtų?
– Cholera kelia rimtą nerimą kai kuriuose pasaulio regionuose, ir būtent labiausiai nerimauju dėl jos galimo plitimo Ukrainoje ir Gazoje. Kiek žinome, šiuo metu nė viename iš šių konfliktinių regionų choleros nėra, tačiau jai ten patekus, ji turbūt išplistų labai greitai ir nusineštų daugybę gyvybių.
Šiuo metu pasaulyje jaučiamas choleros vakcinos trūkumas. Iš dalies dėl to, kad didelė vakcinų gamybos dalis buvo nukreipta į COVID-19, be to, pandemijos metu daug žmonių negalėjo dirbti. Tačiau trūkumo priežastis yra ir išaugusi paklausa – per pastaruosius dvejus trejus metus choleros atvejų smarkiai padaugėjo.
Paprastai pasaulinėse atsargose yra daug choleros vakcinų, tačiau dabar jos, galima sakyti, tuščios – viskas išnaudota, o tai, kas šiuo metu gaminama, jau paskirta toms šalims, kuriose cholera kelia realią grėsmę.
Didžiausią mirčių skaičių tikriausiai sukeltų dar viena didelė gripo pandemija, panaši į 1917 m. Ispaniškąjį gripą. Pastarasis ypač smogė jaunesniems žmonėms, o COVID-19 dažniausiai pražudydavo vyresniuosius.
Ispaniškojo gripo sukelta mirtis buvo itin sunki – plaučiai prisipildydavo skysčiu ir žmonės mirdavo paskendę savo kvėpavimo takuose susikaupusiose išskyrose. Toks virusas teoriškai galėtų pareikalauti daugiau gyvybių nei dauguma kitų infekcijų.
– Kitas pavojus, žinoma, yra tarptautinės kelionės, kaip matėme COVID atveju. Kokias pavojingas „lauktuves“ galime parsivežti iš užsienio?
– Viena didžiausių rizikų keliaujant į užsienį – antibiotikams atsparūs mikroorganizmai, kuriuos kai kurie žmonės apibūdina kaip naujas infekcijas. Tai ligos, kurios egzistavo jau anksčiau, tačiau dabar jų nebegalime veiksmingai gydyti, nes jos tapo atsparios daugeliui vaistų.
Didelė šios problemos dalis siejama su sekso turizmu (turizmo šaka, kai keliautojai į kitą šalį važiuoja tam, kad pasimylėtų su sekso industrijoje dirbančiais žmonėmis) – kaip rodo ankstesnė patirtis, būtent taip paplito vaistams atspari gonorėja.
Kita rimta grėsmė – medicinos turizmas. Tai reiškinys, kai žmonės vyksta į užsienį ieškodami pigesnių plastinių operacijų ar net odontologinių procedūrų. Turime nemažai įrodymų, kad tokiu būdu plinta ir kai kurie itin antibiotikams atsparūs mikroorganizmai, su kuriais šiandien susiduria viso pasaulio sveikatos priežiūros sistemos.
Parengta pagal „BBC Science Focus“.